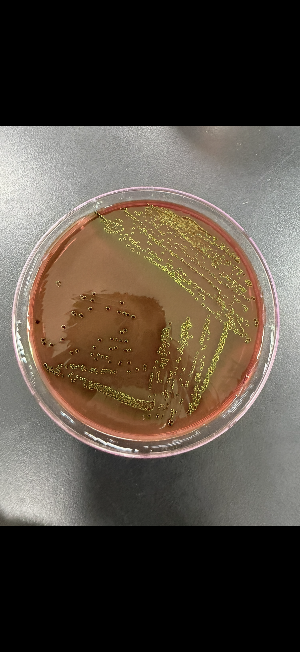
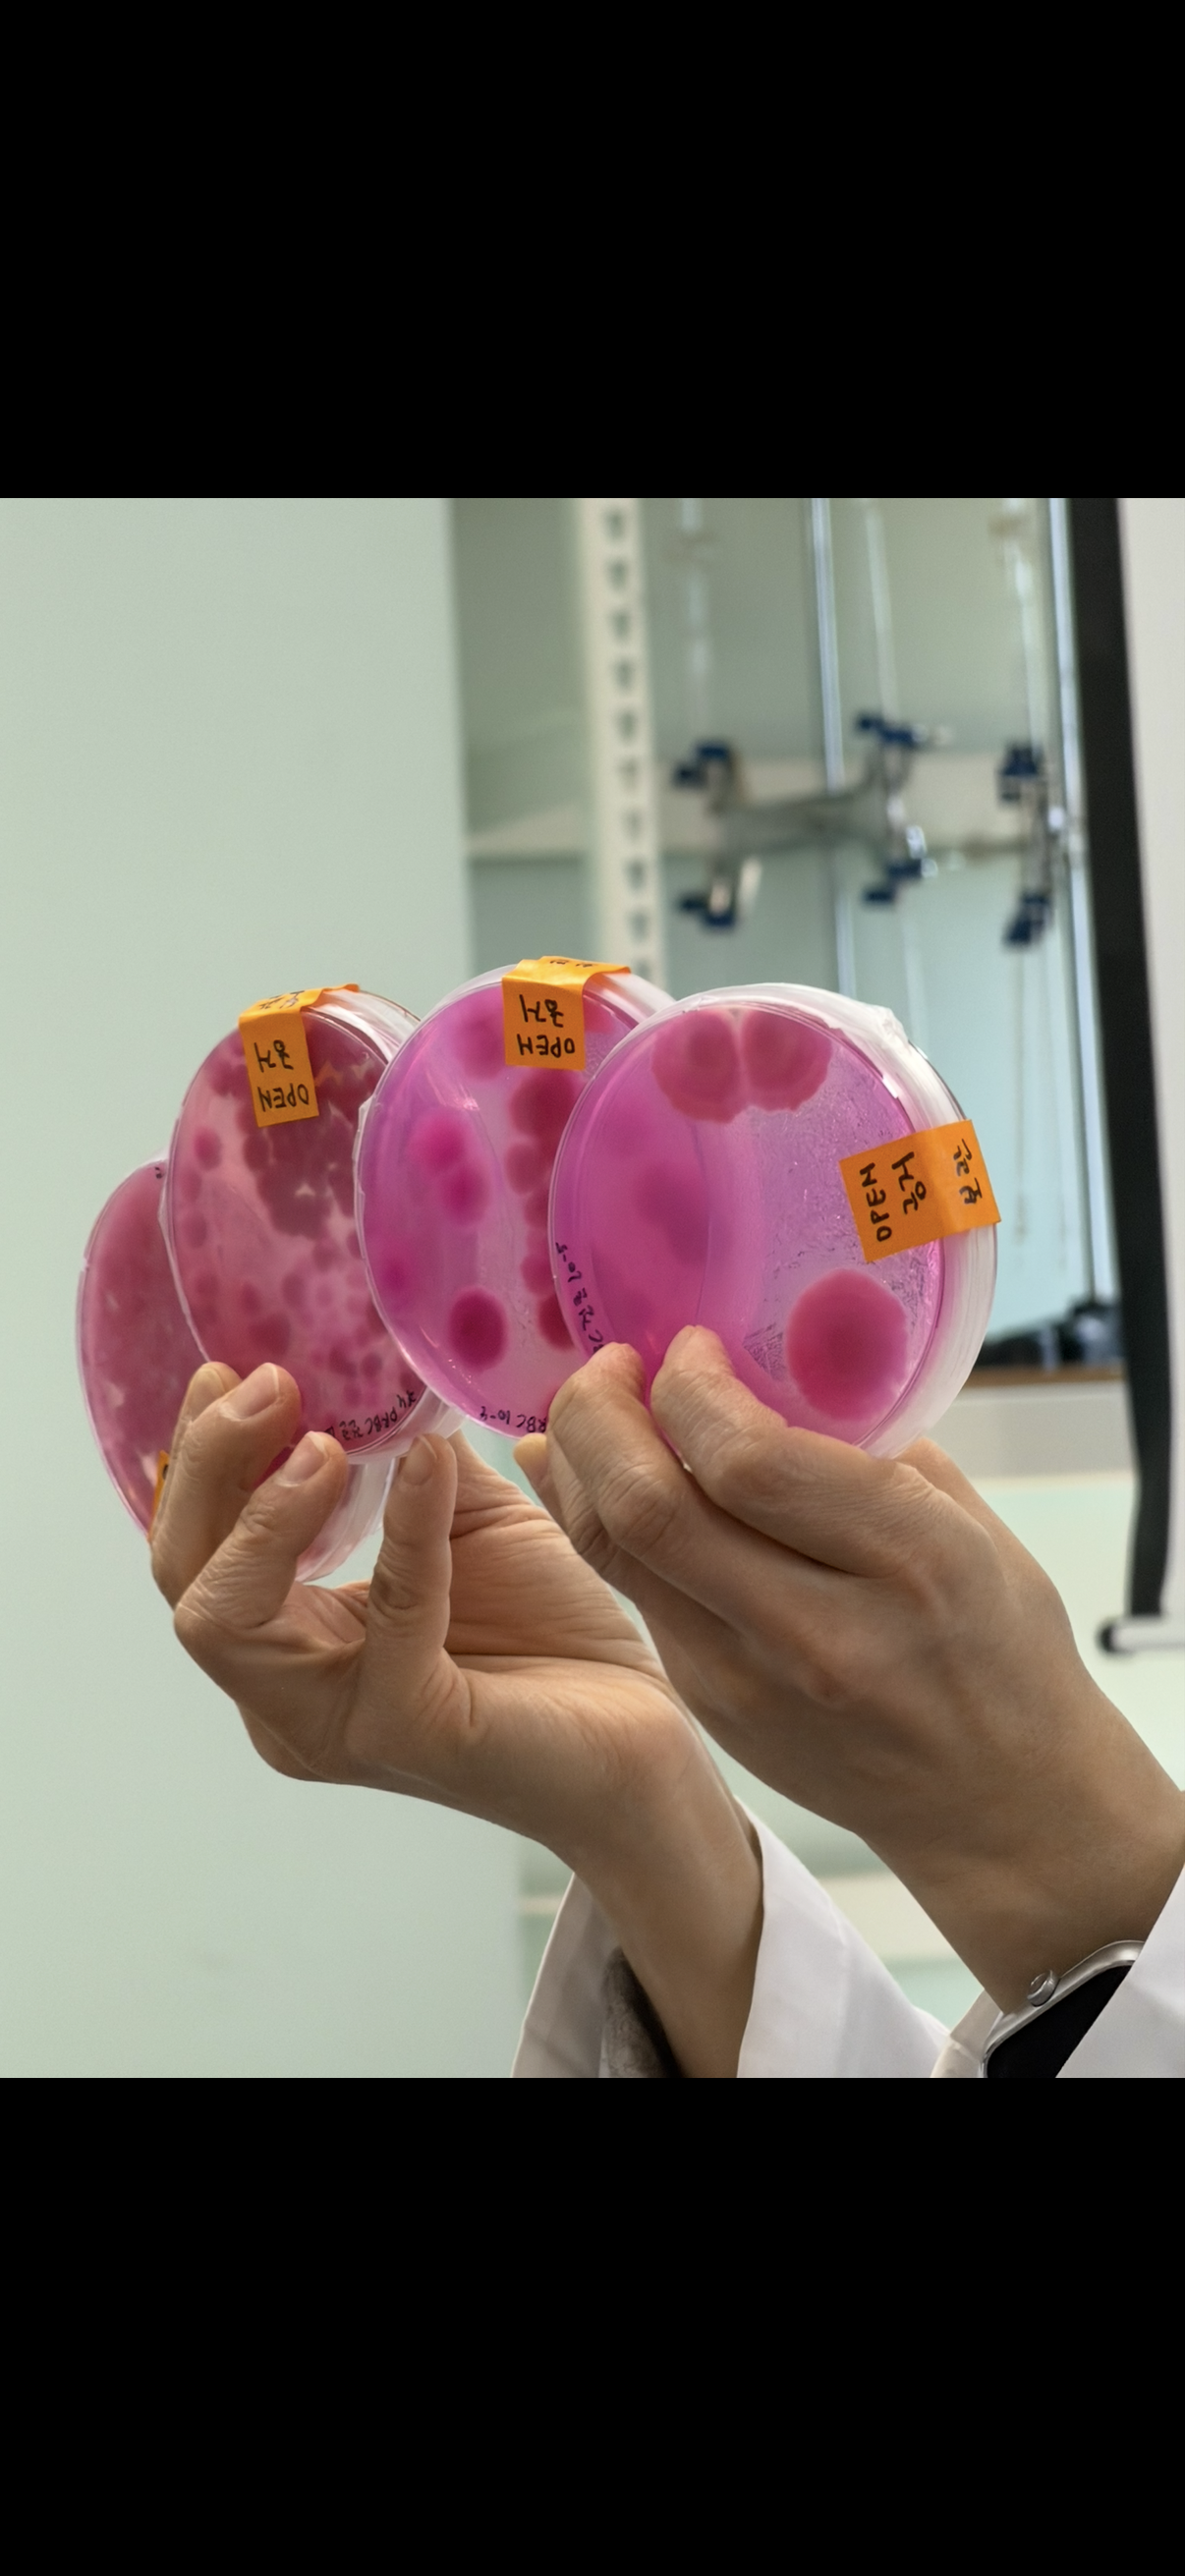

교육 후 한달 이내 수강하신 교육 후기를 작성한 경우에 한해서 경품을 제공해드리고 있습니다.
*교육날짜 : 26.03.11~13
*교육장소 : 서울교육장
*교육명 : 일반미생물(실습)
*성함 : 나준형
(성함을 남겨주셔야 원활한 상품제공이 가능합니다^^)
-----------------------------
아래의 후기작성 양식에 맞춰 글을 10줄 이상 작성, 사진 3장을 함께 첨부해주세요.
※ 사진 업로드 시, 타 교육생의 초상권을 침해하지 않도록 사진편집 부탁드립니다.^^
후기작성 양식
① 해당 교육을 신청하신 계기와 목적은 무엇인가요?
그 전 직장에서 이화학시험 위주로만 하고 깊게 들어갔을때 미생물쪽이 약하다 생각하여 듣고 싶었습니다.
또 잘하면 식품 건기식 분야에서도 일할수도 있을거 같아 들었습니다.
② 해당 교육에 대한 전반적인 느낌은 어떠한가요? (교육 측면 / 시설 및 위치 측면)
쾌적하고, 강사님의 업무 배분 및 적절한 휴식 시간 기초부터 실질적으로 어떻게 접목되고 기초부터
추가 부연 설명까지 디테일 하게 알려주셔서 쉽게 이해할 수 있었습니다.
덕분에 이론 및 실습 과정 격어 재밌었고 소수 정예로 교육받게 되어 재밌었습니다.
③ 가장 도움이 됐거나 인상 깊었던 점은 무엇인가요?(강사 전문성/업무 적용성/네트워크 형성 등)
가장 인상 깊었던 점은 단연 강사님의 학생들의 눈높이에 맞춘 강의였습니다.
미생물 실험이 처음인 사람도 쉽게 이론과 실습을 배울수있을정도로 디테일하게 알려주시며
해깔리면 직접 돌아다니며 설명해주시고 잡아주시는 디테일이 좋아서 초보자도 쉽게 재미있게
배울수 있는 환경이 좋았던 거 같습니다.
덕분에 몰랐었던 생소한 개념들도 듣고 실질적으로 어떻게 이론과 실습을 하면서 적용 시키는지 배울수 있었습니다.
④ 해당 교육을 추천한다면, 그 대상과 이유는 무엇인가요?
식품 및 각종 미생물 분야에서 일을 하고 전공을하며 미생물 실험을 주로하는 품질관리 및 각종 종사가 계열에서
일하시는 분들에게 이해하고 현장에 바로 투입되어 실질적으로 활용할 수 있는 눈높이 교육이 좋았습니다.
실제로 전회사에서 건조필름및 미생물 시험을 몇년간 하였는데 실제 하시는 교육과 하는 방법이 비슷하고 디테일 하게 이론과 실무적으로
교육 하시는 모습에서 여러가지 감정 느끼고 몰랐었던 점들을 배울수 있었습니다.
취업 및 미생물 관련 일하시는 종사자분들이 들으면 좋다 생각들었습니다.

⑤ 향후 정보원의 타 교육과정에 대한 수강계획 혹은 개설되었으면 하는 과정이 있으신가요?
병원성 3종 들을 생각이며 개인적으로는 재직중인사람이거나 평일에 사정상 못드는 사람들도 있어 주말 교육도 있으면 좋겠다는
개인적인 생각이 들었습니다. 재밌고 감사했습니다.
#한국식품정보원 #식품교육